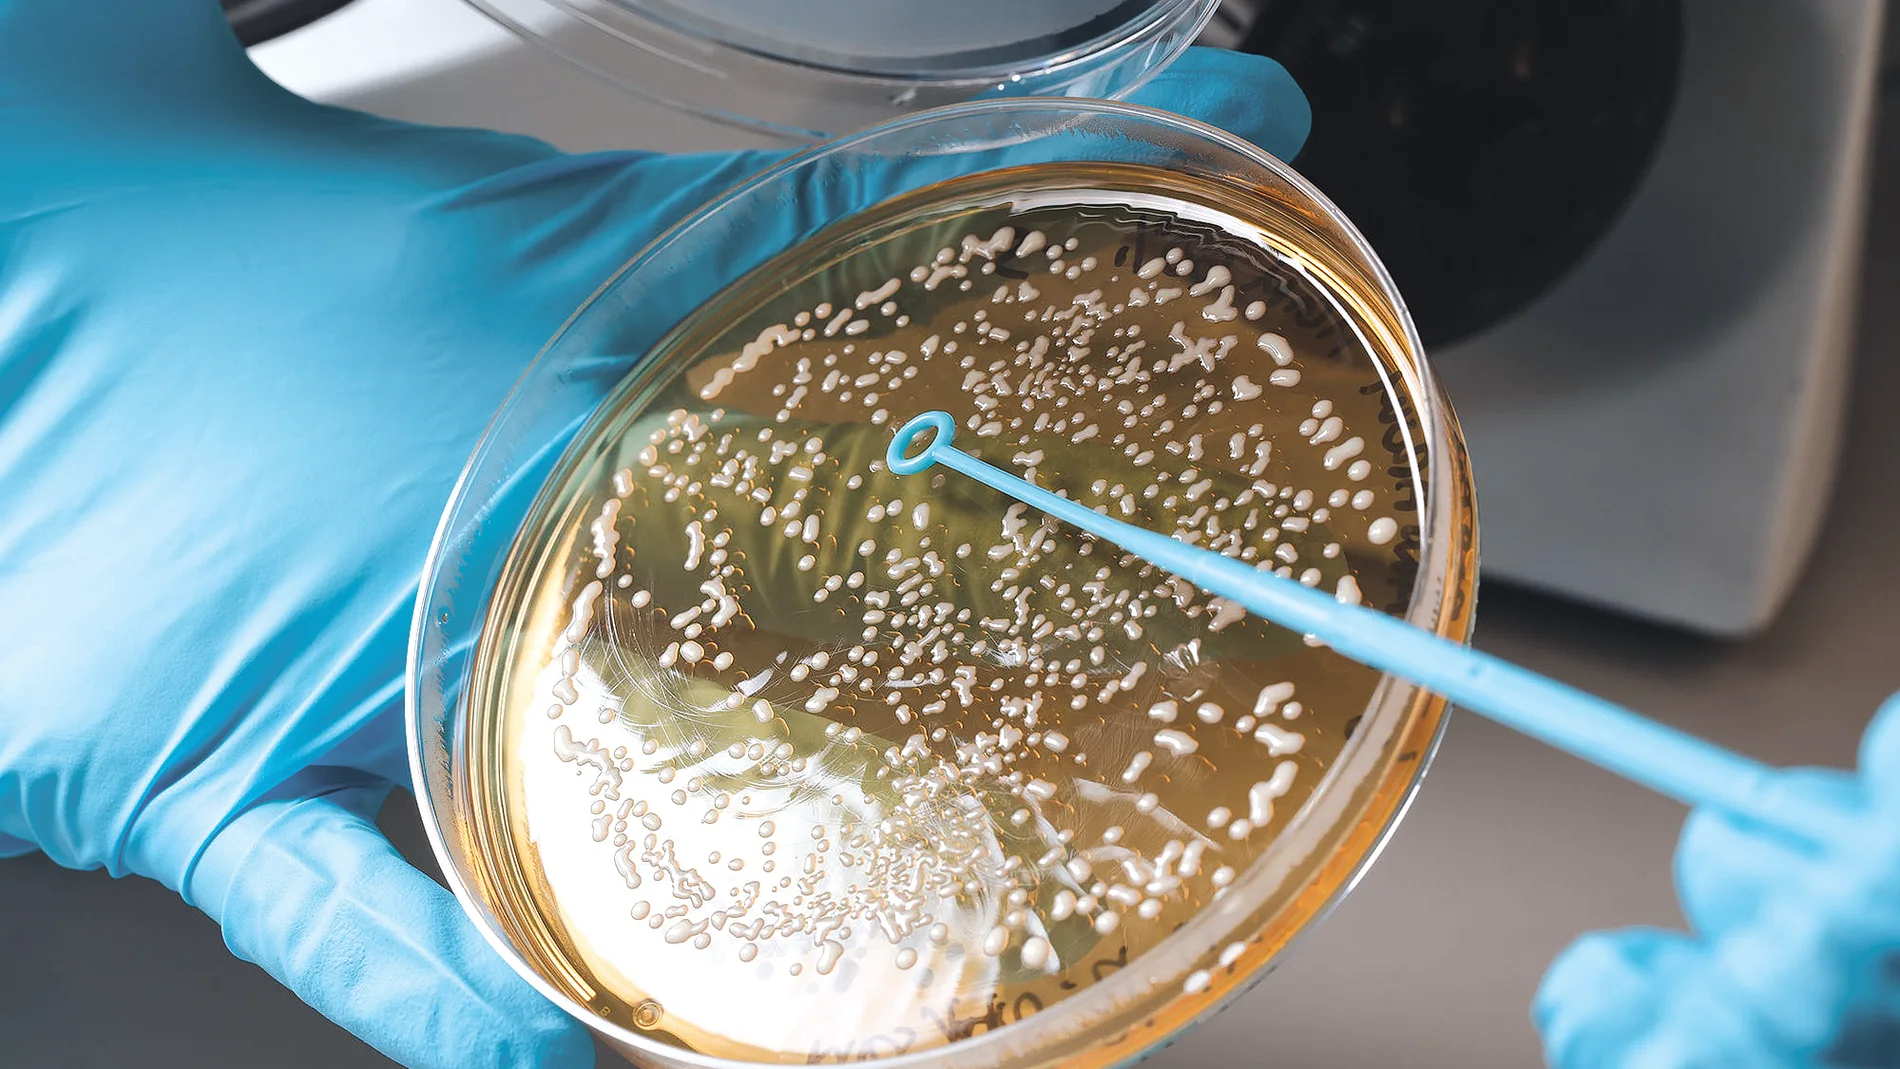
LEV2050 centró los primeros pasos de su actividad en el sector vitivinícola, llevando a cabo estudios de aislamientos, identificación, caracterización y selección de levaduras propias, en diferentes bodegas que apostaron por conocer la biodiversidad existente en su Terroir.

Sección patrocinada por 
Bioquímica
Este nuevo fármaco podría alargar la vida y ya funciona en hongos
De hecho, solo funciona en levaduras, pero plantea nuevos abordajes para el envejecimiento saludable
La medicina ha sido un éxito. Tanto que la gente ya no quiere vivir más, sino vivir mejor y, a ser posible, vivir mejor durante más años. Ya no perseguimos a toda costa la inmortalidad que quitó el sueño al Rey Gilgamesh y abrazamos la caducidad de nuestra especie, como propuso Tolkien al negarnos Valinor. Somos exigentes y estamos deseando leer titulares como el que encabeza la nota de prensa que acaba de presentar la Universidad Queen Mary de Londres: “Nuevo fármaco y clase de enzimas descubiertos con propiedades antienvejecimiento”. Un titular mucho mejor que el que hemos utilizado nosotros, desde luego… si no te importa omitir detalles cruciales y jugar con las expectativas de los lectores, por supuesto.
Y es que, a pesar de que el titular de la Universidad Queen Mary no falta a la verdad, se aprovecha de lo que el público va a interpretar cuando, automáticamente, complete las elipsis de su frase. El fármaco en cuestión parece tener propiedades antienvejecimiento e, incluso, promover el envejecimiento saludable. No obstante, estas propiedades no se han demostrado en humanos. Ni siquiera en mamíferos. Es más, ni siquiera se han medido en animales, sino en hongos (concretamente, en levaduras). El estudio, que ha sido publicado en la revista Communications Biology, supone un hito interesante e invita a explorar nuevos abordajes para retrasar el envejecimiento. No obstante, queda una verdadera epopeya antes de poder sugerir efectos en animales, e incluso mucho más en humanos.
Expectativas peligrosas
Las sustancias estudiadas han sido dos. Por un lado, el rapalink-1, un fármaco que todavía no ha sido aprobado para su uso en humanos, pero que está siendo estudiado como posible tratamiento de algunos tipos de tumores. Por otro lado, dos productos del metabolismo, la agmatina. De hecho, uno de los investigadores, el Dr. Rallis, añade hacia el final de la nota de prensa que: “Debemos ser cautelosos respecto al consumo de agmatina para fines de crecimiento o longevidad. Nuestros datos indican que la suplementación con agmatina puede ser beneficiosa para el crecimiento solo cuando ciertas vías metabólicas relacionadas con la descomposición de la arginina están intactas. Además, la agmatina no siempre promueve efectos beneficiosos, ya que puede contribuir a ciertas patologías”.
Una advertencia que ha sido ubicada en el texto tan lejos del titular como ha sido posible y que indica que, incluso a muchos años de un posible estudio en humanos, ya tenemos claro que algunas de estas sustancias están lejos de ser una panacea. En cualquier caso, una vez aclarada la deliberada ambigüedad de la nota de prensa, podemos entrar en detalle.
¿Qué han demostrado realmente?
Los investigadores han administrado rapalink-1 a cultivos de levaduras y han descubierto que ralentizaba su crecimiento y prolongaba significativamente su esperanza de vida. Es más, han identificado la vía a través de la cual actúa, concretamente inhibiendo la vía TOR, que está implicada en multitud de procesos, entre ellos, el crecimiento y la diferenciación celular. Hasta aquí, el resultado está bastante alineado con lo que muestran sus estudios oncológicos. La novedad es que esta investigación ha revelado que un conjunto de enzimas llamadas agmatinasas son claves en estos beneficios de la rapalink-1. En condiciones normales, la vía TOR inhibe la agmatinasa pero, en presencia del rapalink-1, la vía TOR no puede actuar y la agmatinasa se acumula.
Y aquí está la clave, porque al estar presentes, estas enzimas enzimas descomponen una molécula de nuestro metabolismo conocida como “agmatina” formando otras sustancias. Y, como han podido ver en este estudio, cuando la enzima está inactiva el crecimiento celular se acelera y las levaduras viven menos tiempo. Dicho de otro modo, los productos de degradar la agmatina moderan el crecimiento de las células y, por lo tanto, el rapalink-1, que aumenta la actividad de la enzima agmatinasa, aumenta también los productos de esa degradación, frenando el crecimiento celular y promoviendo la longevidad.
Una conclusión a la cual, el Dr. Rallis añade que “al demostrar que las agmatinasas son esenciales para un envejecimiento saludable, hemos descubierto una nueva capa de control metabólico sobre TOR (una que puede estar conservada en humanos)”, dijo el Dr. Rallis. “Dado que la agmatina es producida por la dieta y los microbios intestinales, este trabajo puede ayudar a explicar cómo la nutrición y el microbioma influyen en el envejecimiento”. Un planteamiento mucho más comedido que el que podíamos leer en el titular y que inspira a seguir investigando en busca de nuestra piedra filosofal.
QUE NO TE LA CUELEN:
- Los titulares son complicados, pero quien los escribe no solo es responsable de su valor de verdad, sino de cómo los interpretará el público general y, aunque uno no puede anticipar todas las malinterpretaciones, jugar con ambigüedades y omisiones augura un mal resultado.
REFERENCIAS (MLA):
- Kumar, Juhi, Kristal Ng, and Charalampos Rallis. “Rapalink-1 Reveals TOR-Dependent Genes and an Agmatinergic Axis-Based Metabolic Feedback Regulating TOR Activity and Lifespan in Fission Yeast.” Communications Biology, 29 Sept. 2025, doi:10.1038/s42003-025-08731-3.
✕
Accede a tu cuenta para comentar


